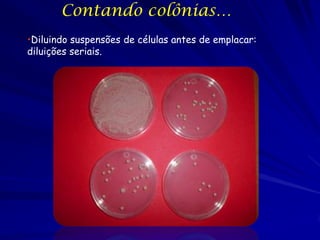
Contando colônias…
•Diluindo suspensões de células antes de emplacar:
diluições seriais.

O documento discute métodos para estimar o crescimento microbiano, incluindo contagens de células viáveis e não viáveis, medições de turbidez e uso de culturas contínuas. Aborda parâmetros de crescimento exponencial como taxa de crescimento, tempo de geração e mortalidade entre duplicações. Também descreve as fases do ciclo de crescimento microbiano e a regulação dependente da densidade da população.